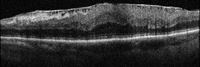
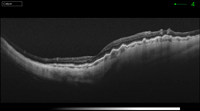

Volumen 23 - Número 2 - Abril - Junio 2015
Pliegues coroideos
C. Veiga1, S. Muñoz1, D. Lorenzo2
1Hospital Universitari de Bellvitge
2Altahaia Xarxa Assistencial Universitària de Manresa
2Altahaia Xarxa Assistencial Universitària de Manresa
CORRESPONDENCIA
Carla Veiga
E-mail: cavesati@gmail.com
E-mail: cavesati@gmail.com
RESUMEN
Los pliegues coroideos se presentan como líneas claras y oscuras alternantes en el polo posterior y aparecen a consecuencia de fenómenos mecánicos entre las capas de coroides y retina. Pueden detectarse de forma asintomática o producir errores refractivos, metamorfopsias o pérdida visual y pueden ser idiopáticos o asociarse a patología ocular, orbitaria o sistémica. En consecuencia, es preciso realizar una completa evaluación del paciente en búsqueda de la etiología subyacente. Las exploraciones más útiles para su identificación son la angiografía fluoresceínica, la ecografía ocular, las pruebas de neuro-imagen, y también las nuevas técnicas no invasivas como la tomografía de coherencia óptica y la autofluorescencia de la retina.
RESUM
Els plecs coroïdals es presenten com línies clares i fosques alternants al pol posterior i es produeixen per fenòmens mecànics entre les capes de la coroides i la retina. Es poden detectar en un pacient asimptomàtic o associats a errors refractius, metamorfòpsies, o pèrdua visual. La seva causa és idiopàtica o relacionada amb processos oculars, orbitaris o sistèmics, per tant, quan es detecten cal fer una avaluació completa per identificar l'etiologia sots-jacent. Les exploracions de major interès són l'angiografia fluoresceínica, l'ecografia ocular, els estudis de neuro-imatge, i també les noves tècniques no invasives como la tomografia de coherència òptica i l'auto-fluorescència de la retina.
ABSTRACT
Choroidal folds are alternating dark and clear lines in the posterior pole induced for mechanical phenomena between choroid and retinal layers. Either asymptomatic or associated with refractive errors, metamorphopsia or visual loss, they may be idiopathic or related to ocular, orbit or systemic disorders. When detected, a complete study is warranted to identify the underlying cause. The most useful diagnostic techniques are fluorescein angiography, eye ultrasonography, and neuroimaging. The newest non-invasive procedures as optic coherence tomography and retina autofluorescence also have an emerging role.
Introducción
Los pliegues coroideos son anomalías funduscópicas que se caracterizan por la aparición de líneas alternas claras y oscuras en el polo posterior. Se asocian a fenómenos mecánicos que producen que las capas coroideas internas, la membrana de Bruch, el epitelio pigmentario de la retina (EPR) y las capas externas de la retina se replieguen y formen ondulaciones1.No se trata de una enfermedad definida, sino un hallazgo clínico infrecuente que puede ser idiopático o secundario a patología ocular, orbitaria o sistémica. Así pues, cuando se detectan es preciso realizar una completa evaluación del paciente en búsqueda de la etiología subyacente. Suelen presentarse de manera asintomática y su manejo dependerá de la causa principal.
Fisiopatología
El mecanismo de producción más frecuente es la compresión escleral, que deforma las capas coroideas internas, la membrana de Bruch, el EPR y la retina neurosensorial. También se han descrito otras causas relacionadas con las características biomecánicas de la esclera, coroides y retina, como la congestión coroidea que se transmite hacia capas más internas o cambios en la tensión de la membrana de Bruch1. En resumen, cualquier proceso intra u extraocular que altere la relación anatómica entre esclera y capas internas oculares puede ocasionar estos pliegues.Presentación clínica y hallazgos exploratorios
Aunque la mayoría de los pacientes son asintomáticos, pueden producir cambios refractivos (hipermetropía adquirida), metamorfopsias y pérdida visual. Si se cronifican causan una maculopatía con progresivo deterioro de la visión central2.En el examen del fondo de ojo se evidencian unas líneas paralelas correspondientes a los pliegues. Las más claras, habitualmente amarillas, son las crestas, y traducen un adelgazamiento del EPR. Por otro lado, las más oscuras se corresponden con los valles, con el EPR más compactado y congestivo. La disposición de las ondulaciones es variable y depende de la etiología asociada. La mayoría son horizontales aunque en casos de hipotonía ocular son multidireccionales. En membranas neovasculares adoptan una disposición radial, y cuando se asocian con edema de papila son circunferenciales alrededor del disco óptico.
La angiografía fluoresceínica tiene un papel destacado en los pliegues de reciente aparición porque revela el patrón característico de hiperfluorescencia en las crestas combinada con hipofluorescencia en los valles (Figura 1). La tomografía de coherencia óptica (OCT) tiene una especial utilidad en diferenciar los pliegues coroideos de los pliegues retinianos secundarios a patología de la interfase vítreo-retiniana (Figura 2A y Figura 2B)3. Los últimos son más finos, irregulares y menos pigmentados; no se visualizan en la angiografía y la OCT revela su causa (membrana epirretiniana, tracción vítreo-macular…). Recientemente se ha demostrado que los grosores coroideos subfoveales medidos con OCT son mayores en los pacientes con pliegues en comparación con la población normal4. La autofluorescencia es una técnica útil y además no invasiva en la demostración del típico patrón que muestra la angiografía. Se diferencia de ella que el patrón de líneas claras y oscuras aparece de forma inversa (las crestas son hipoautofluorescentes y los valles hiperautofluorescentes)5.

Figura 1. Angiografía fluoresceínica en fase venosa precoz (A y B) y fondo de ojo (C) . En el ojo izquierdo se aprecian las líneas horizontales con franjas hipofluorescentes e hiperfluorescentes correspondientes a los valles y crestas (cortesía Dra. Fossas-Dr. Arruga).
Figura 2A. OCT-SD pliegues retinianos producidos por una membrana epirretiniana.
Figura 2B. OCT pliegues coroideos en el caso de una maculopatía por hipotonía en una cirugía filtrante de glaucoma.
La ecografía ocular y las pruebas de neuroimagen (TC y RMN) están indicadas para determinar causas extraoculares de esta anomalía como tumores orbitarios e hipertensión intracraneal.
Etiología
El diagnóstico diferencial es amplio porque existen múltiples patologías causantes de su aparición. Para sistematizar el manejo diagnóstico, se describen las causas unilaterales y bilaterales.Pliegues coroideos bilaterales
- Hipermetropía adquirida: es la causa más frecuente y aparece principalmente en pacientes a partir de los 40 años. Se produce por la reducción progresiva de la longitud axial ocular y suele ser un hallazgo casual. El manejo incluye la corrección del error refractivo. Excepcionalmente estos pacientes pueden presentar hipertensión craneal, sobre todo si los pliegues se asocian con edema de papila. Por este motivo, en el contexto clínico de sospecha, está indicado practicar pruebas de imagen cerebral y punción lumbar como parte del estudio.
- Hipertensión craneal: los pacientes con papiledema (edema de papila secundario a hipertensión intracraneal) pueden presentar pliegues coroideos asociados como se ha mencionado anteriormente. Suelen ser horizontales en la región macular y circunferenciales en los cuadrantes nasales del disco óptico (Figura 3 y Figura 4). Muy infrecuentemente pueden preceder al papiledema, por tanto, su presencia obliga a descartar la hipertensión craneal antes de etiquetarlos como idiopáticos6. También pueden aparecer pliegues coroideos en los casos de pseudopapiledema por drusas del disco óptico.
- Fármacos: algunos fármacos como el topiramato (antiepiléptico y antimigrañoso) los producen por un mecanismo de congestión vascular7.
- Idiopáticos: son un hallazgo casual en la exploración de rutina de un paciente asintomático. Tienen visiones conservadas aunque pueden presentar diversos errores refractivos. Los pliegues adoptan una disposición horizontal y están simétricamente distribuidos por todo el polo posterior (Figura 5 y Figura 6). El diagnóstico es de exclusión y se recomienda un cuidadoso seguimiento hasta descartar causas secundarias8.

Figura 3. Pliegues coroideos horizontales bilaterales en la mácula. Se acompaña de palidez papilar posterior a la resolución del papiledema.

Figura 4. Pliegues coroideos circulares alrededor del nervio óptico en un caso con papiledema crónico-atrófico activo.

Figura 5. Pliegues en el polo posterior y borrosidad de ambos discos ópticos en un paciente con visión fluctuante. Tras los estudios pertinentes (ecografía ocular, angiografía) se llegó a la conclusión que era un pseudopapiledema sin drusas asociado a pliegues con hipermetropía e importante aplanamiento del polo posterior (cortesía Dr. Arruga).

Figura 6. Una paciente de 73 años consultó por cefalea intensa meses atrás. En el momento del estudio solo se apreciaron los pliegues corio-retinianos temporales a la mácula y leve palidez del disco óptico derecho. Las evaluaciones complementarias no detectaron causas asociadas (hipertensión intracraneal, alteraciones orbitarias, escleritis).
Pliegues coroideos unilaterales
- Hipotonía: produce pliegues coroideos anchos y mal definidos con distribución multidireccional. Se puede asociar a complicaciones quirúrgicas (fuga por heridas, hiperfiltración tras cirugía de glaucoma), traumatismos, uveítis, desprendimiento de cuerpo ciliar, entre otros. Tanto la angiografía como la ecografía son útiles para el diagnóstico. El manejo consiste en corregir la causa de la hipotonía, cuando ésta ha sido prolongada pueden quedar líneas de pigmento epitelial residuales (Figura 7).

Figura 7. Hipotonía ocular en paciente con cirugía filtrante de glaucoma en ambos ojos. Se aprecia asimetría en los pliegues que son más prominentes en el ojo izquierdo, afectan la mácula y se asocian con borramiento y elevación del disco óptico.
- Neovascularización coroidea: la neovascularización coroidea secundaria a degeneración macular u otros procesos puede formar pliegues de carácter radial en el contexto de grandes lesiones en su fase cicatricial7.
- Neoplasias coroideas: el melanoma uveal y las metátasis coroideas son los tumores coroideos que más frecuentemente producen pliegues. Se presentan como ondulaciones irregulares de disposición radial alrededor de la lesión y pueden desaparecer o no tras el tratamiento de la tumoración subyacente. Otras causas menos habituales son los hemangiomas y osteomas1. La prueba más útil para confirmar el diagnóstico es la ecografía.
-
Inflamaciones:
- Escleritis posterior: cursa con dolor, pérdida visual, proptosis y limitación de los movimientos oculares y puede ser idiopática o secundaria a enfermedades sistémicas (artritis reumatoide, granulomatosis de Wegener). Los pliegues son producidos por la congestión coroidea asociada a la inflamación escleral o aparecen como consecuencia de la retracción cicatricial escleral posterior. El diagnóstico, una vez más, se basa en la angiografía y ecografía, que detecta la presencia de fluido subtenoniano. El manejo incluye la corticoterapia e inmunosupresión en los casos secundarios.
- Síndrome de Vogt-Koyanagi-Harada: en este caso la inflamación ocular es bilateral pero asimétrica y clínicamente se presenta de manera similar a la escleritis posterior6. Recientemente se ha demostrado mediante OCT de alta resolución que la presencia de pliegues coroideos se relaciona con el mayor engrosamiento de la coroides en la fase aguda de la enfermedad y, que a su vez se relaciona con una mayor duración del episodio inflamatorio9 (Figura 8).

Figura 8. Pliegues coroideos bilaterales en la fase uveítica aguda de una paciente de 40 años con la enfermedad de Vogt-Koyanagi-Harada. En las retinografías destaca la presencia de múltiples focos de desprendimientos serosos localizados en polo posterior y el edema de papila en ambos ojos.
- Tumores orbitarios: los causan aquellas lesiones que ocupan el espacio peri o retrobulbar, en contacto con la parte posterior del globo ocular. Si son intraconales producen hipermetropía y ondulaciones radiales alrededor de la papila. Por el contrario, si son extraconales originan astigmatismo y pliegues concéntricos alrededor del nervio. Es preciso practicar pruebas de imagen si se sospecha esta causa, el tratamiento puede contribuir a la normalización del fondo de ojo (Figura 9 y Figura 10).

Figura 9. Fondo de ojo con de paciente que consultó por cambió refractivo unilateral (hipermetropía) y exoftalmos progresivo. Se aprecian pliegues oblicuos en el ojo izquierdo. El estudio de TC orbitario reveló una tumoración intraconal unilateral compatible tumor fibroso solitario de la órbita.

Figura 10. Enfermedad de Erdheim-Chester con ocupación orbitaria bilateral. Figura 10A. Fondo de ojo. Los pliegues coroideos asociados tienen una disposición horizontal y se localizan en la mácula. Figura 10B. TC orbitaria corte axial, se aprecia la ocupación del espacio intraconal por una lesión hiperdensa que aplana el polo posterior de ambos globos oculares.
- Dispositivos esclerales: las bandas esclerales implantadas para el tratamiento del desprendimiento de retina o las placas de radioterapia en el caso del melanoma de coroides pueden deformar la superficie escleral. Comprometen la visión si afectan el área macular, son más evidentes en el periodo postoperatorio y suelen ir resolviendo con el paso del tiempo.
Conclusiones
Los pliegues coroideos están causados por múltiples etiologías lo que obliga a un abordaje diagnóstico amplio (Tabla 1). Las exploraciones clásicas como la angiografía fluoresceínica, y la neuroimagen (TC y RM), siguen siendo válidas para su estudio. Las aportaciones de las nuevas tecnologías como la OCT y la autofluorescencia permiten su detección de manera no invasiva.

Tabla 1. Resumen de las principales etiologías de los pliegues coroideos.
Bibliografía
- Gasperini J, Elliot D, Cunningham ET. How to Recognize and treat chorioretinal folds. Review of Ophthalmology. 2006;13(11):137.
- Olsen T, Palejwala N, Lee L, et al. Chorioretinal folds: associated disorders and a related maculopathy. Am J Ophthalmol. 2014;157:1038-47.
- Giuffrè G, Distefano MG. Optical coherence tomography of chorioretinal and choroidal folds. Acta Ophthalmol. 2007;85:333-6.
- Ghodrati F, Choudhry N, Wong R. Choroidal thickness in eyes with choroidal folds. Poster paper in ARVO 2015. Program number 2785.
- Fine HF, Cunningham ET, Kim E, et al. Autofluorescence imaging findings in long-standing chorioretinal folds. Retin Cases Brief Rep. 2009;3:137-9.
- Musetti D, Nicolò M, Bagnis A, Traverso CE. Chorioretinal folds: associated disorders and a related maculopathy. Am J Ophthalmol. 2014;158:409.
- Mango C, Garraf D, Schwartz S. Choroidal Folds. En Holz F, Spaide R. Medical Retina, Essentials in Ophthalmology. Berlín: Springer; 2005;65-76.
- Millà E, Arruga J, Sedó S. Foto diagnóstica. Annals d'Oftalmologia. 1994;4:137-8.
- Tsuboi K, Nakai K, Iwashashi C, et al. Analysis of choroidal folds in acute Vogt-Koyanagi-Harada disease using high-penetration optical coherence tomography. Graefes Arch Clin Exp Ophthalmol. 2015; DOI 10.10007/s00417-015-2945-y

